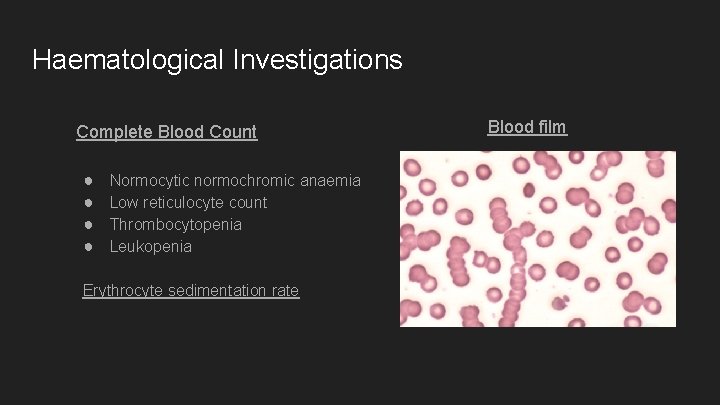
Haematological Investigations Complete Blood Count ● ● Normocytic normochromic anaemia Low reticulocyte count Thrombocytopenia

Multiple Myeloma UWI Mona Brittany Smith Dea Thomas

Multiple Myeloma UWI Mona Brittany Smith Dea Thomas

Case Summary 15/04/18 ● H. B who is a 74 year old female presented with: ○ Back pain x 2/52 ○ Not talking x 4/7 ○ Not eating x 4/7 ○ Not walking (this am) Of note, the patient had received medication for a UTI prior to admission. The family has also stated that H. B has not passed stool for 1 month. On examination her mucus membranes were pale and moist and her motor examination was 3/5 and 4/5 throughout for lower limb and upper limb respectively. Urine dipstick showed trace proteins.

Lab Results: 15/ 04/ 2018 Patient’s results Normal values Hb (g/d. L) 5. 4 11. 5 - 15. 5 PCV (%) 17 36 -48 MCHC (g/d. L) 31 30 -35 1. 95 3. 9 -5. 6 MCV (f. L) 89 80 -95 MCH (pg) 28 27 -34 WBC (x 10^9/L) 10. 5 4 -11 PLT (x 10*9/L) 132 150 -450 RBC (x 10^12/L)

15/ 04/ 2018 Na 142 mmol/L (135 – 145) K 4 mmol/L (3. 5– 5. 0) Cl 92 mmol/L (95– 105) HCO 320. 5 mmol/L (20– 28) Urea 21. 6 mmol/L (2. 5 – 6. 7) Creat 556 μmol/L (9 - 124) Uric Acid ? Ca PO 42 T Prot. Alb Globulin LDH T Bili ALT AST ? ? 113 g/L (64 – 84) 29 g/L (38 – 52) 84 g/L 584 U/L (109 -193) 8 μmol/L (< 18) 13 U/L (6 -37) 40 U/L (0 -30)

20/ 04/ 2018 Patient’s results Normal values Hb (g/d. L) 4. 4 11. 5 - 15. 5 PCV (%) 14. 5 36 -48 MCHC (g/d. L) 30. 3 30 -35 RBC (x 10^12/L) 1. 59 3. 9 -5. 6 MCV (f. L) 91. 2 80 -95 MCH (pg) 27. 7 27 -34 WBC (x 10^9/L) 10. 48 4 -11 136 150 -450 PLT (x 10*9/L)

20 /04/ 2018 Na K Cl HCO 3 Urea Creat Uric Acid 151 mmol/L (135 – 145) 3. 8 mmol/L (3. 5– 5. 0) 107 mmol/L (95– 105) 23. 3 mmol/L (20– 28) 39. 2 mmol/L (2. 5 – 6. 7) 712 μmol/L (9 - 124) 1. 20 mmol/L (0. 20 – 0. 47) Ca 3. 6 mmol/L (2. 25 – 2. 75) PO 421. 9 mmol/L (0. 8 – 1. 4) T Prot. 104 g/L (64 – 84) Alb 24 g/L (38 – 52) Globulin 80 g/L LDH 672 U/L (109 -193) T Bili 6 μmol/L (< 18) ALT 23 U/L (6 -37) AST 61 U/L (0 -30)

Multiple Myeloma

Multiple Myeloma Neoplastic monoclonal proliferation of bone marrow plasma cells characterized by the presence of : ○ monoclonal protein in serum and/or urine ○ lytic bone lesions ○ plasma cell accumulation in the bone marrow

Multiple Myeloma ● When there are multiple plasmacytomas inside or outside bone, this condition is also called multiple myeloma. ○ Plasmacytomas are localized tumors composed of plasma cells, which can grow intramedullary, extramedullary or soft-tissue.



Epidemiology ● According to International Myeloma Foundation there approximately 230, 000 persons affected worldwide ● Peak incidence in the 7 th decade of life ● M>F ● Incidence higher in people of African descents. https: //www. myeloma. org/what-is-multiple-myeloma

Aetiology ● The cause of myeloma is not known ● Myeloma has been seen more commonly than expected among farmers, wood workers, leather workers and those exposed to petroleum products. ● Chromosomal alterations have been found in patients with myeloma: -hyperdiploidy -13 q 14 deletions -translocations t( 1 l; 14)(q 13; q 32), t(4; 14) ( p 1 6; q 32), and t( l 4; 1 6) -17 p 1 3 deletions.

Aetiology ● Strong evidence in switch recombination errors , therefore error in the genetic mechanism to change antibody heavy chain isotype. ● Genome sequencing studies fails to identify any recurrent mutation with >20% frequency. -N-ras, K-ras and B-raf mutations are most common and combined occur in >40% of patients. ● Interleukin (l. L) 6 may play a role in driving myeloma cell proliferation.

Classification Type of monoclonal protein Relative Frequency (%) Ig. G 60% Ig. A 20% Light chains only 19% Ig. D, Ig. E or non-secretory 1%

Pathophysiology ● MM cells produce abnormal immunoglobulins ● Bind to bone marrow stromal cells which stimulate growth and proliferation of MM cells within the bone marrow

Bone Pain ● Due to the expanding population of plasma cells ● Most common symptom (70%) ● Precipitated by movement ● Bone disease: ○ Activation of osteoclasts and suppression of osteoblast ○ Lytic lesions (maybe palpable) ○ Hypercalcemia ○ Pathological fractures ○ Vertebral collapse – spinal cord compression

Immunoparesis ● Recurrent infections – pneumonias, pyelonephritis, UTI ● Deficient antibody production ○ Diffuse hypogammaglobinemia if M protein is excluded ○ Poor antibody response ○ Increased destruction of the immunoglobulins ● Abnormal cell-mediated immunity and neutropenia ● Abnormal complement function

Renal failure ● 25% of patients. 50% have some kind of renal damage. ● Causes ● ● ● ● Cast nephropathy Light chain toxic effects Hypercalcemia Glomerular deposition of amyloid Hyperuricemia Recurrent infections Proteinuria ● ● Bence - Jones proteinuria Non – selective proteinuria if glomerular damage

Normocytic Normochromic Anaemia ● ~80% of patients ● Lethargy, weakness, dyspnea, pallor, tachycardia ● Causes ● ● ● Replacement and extension of normal marrow by myeloma cells Inhibition of haematopoiesis by tumour factors Decreased erythropoietin production by the kidney

Hypercalcemia ● ● ● Stones ● Renal calculi ● Psychiatric moans ● Confusion ● Mental disturbances ● Depression ● Lethargy Polyuria Polydipsia Muscle weakness Bones – bone pain Abdominal groans ● Constipation ● Pancreatitis ● ● ●

Other Clinical Features ● Abnormal bleeding tendencies ○ Interference with platelet function and coagulation factors ○ Thrombocytopenia occurs in advances disease ● Amyloidosis (5%) ○ Features of macroglossia, carpal tunnel syndrome and diarrhoea ● Hyperviscosity syndrome (2%) ○ Purpura, haemorrhages, visual failure, CNS symptoms, neuropathies, heart failure, DVT ● Folate and B 12 Deficiency


Requires 1 major + 1 minor criteria OR 3 minor

Active vs Smouldering Myleloma

End – organ Damage
Haematological Investigations Complete Blood Count ● ● Normocytic normochromic anaemia Low reticulocyte count Thrombocytopenia Leukopenia Erythrocyte sedimentation rate Blood film

Biochemical Investigations Urea and Electrolytes ● ● Hypercalcemia Pseudohyponatremia Elevated BUN and Creatinine Elevated uric acid Serum Proteins ● High Total proteins ● Low albumin ● High globulins Normal ALP (unless fractures) Prognostic Markers ● LDH ● ß 2 Microglobulin ● CRP

24 Hour Urine Collection ● Proteinuria ● Bence-Jones ● >1 g in 24 h is a major criteria ● Note: Dipstick is not sensitive for Bence-Jones proteins due to renal catabolism of the light chains ● Creatinine clearance ● Severity of renal impairment

Electrophoresis and Immunofixation Serum Protein Electrophoresis Immunofixation

Urine Electrophoresis

Radiographic Studies ● Skull ● Long bones ● Spine ● Lytic lesions ● Multiple ● Round ● Punched out ● Bone scan normal

Other Imaging studies ● Magnetic Resonance Imaging ● Thoracic and lumbar spine lesions ● Cord compressions ● Indicated when symptomatic ● Positron Emission Tomography

Bone Marrow Biopsy Abundant Atypical Plasma Cells

Staging Revised – ISS takes into account serum LDH

Differential diagnosis ● Waldenstrom’s macroglobulinemia ● Monoclonal gammopathy of undetermined significance

Treatment 1. 2. Systematic treatment to prevent progression • Induction • Consolidation • Maintenance • Autologous stem cell transplant to allow for intense chemotherapy regimen Symptomatic supportive care to prevent morbidity

Treatment Algorithm Elderly patients (age > 70 y), patients with significant cardiopulmonary problems and other severe comorbidities are not eligible for SCT.
![Supportive Care ● Bisphonates [Ex. Zoledronate 4 mg once a month] ● Decrease osteoclastic Supportive Care ● Bisphonates [Ex. Zoledronate 4 mg once a month] ● Decrease osteoclastic](http://slidetodoc.com/presentation_image_h2/77e8beedc506d49d47e456295d5b32e4/image-39.jpg)
Supportive Care ● Bisphonates [Ex. Zoledronate 4 mg once a month] ● Decrease osteoclastic activity ● Plasmapheresis to clear light chains in renal injury ● Monitoring for and early therapy of UTIs ● Glucocorticoids in spinal cord compression ● Erythropoietin and haematinics for anaemia

Our Patient Ordered Investigations ● ● ● Biochemistry Serum protein electrophoresis 24 hour urine collection for Bence Jones proteins Skeletal survey Group and cross match

20 /04/ 2018 - Results Na K Cl HCO 3 Urea Creat Uric Acid 151 mmol/L (135 – 145) 3. 8 mmol/L (3. 5– 5. 0) 107 mmol/L (95– 105) 23. 3 mmol/L (20– 28) 39. 2 mmol/L (2. 5 – 6. 7) 712 μmol/L (9 - 124) 1. 20 mmol/L (0. 20 – 0. 47) Ca 3. 6 mmol/L (2. 25 – 2. 75) PO 421. 9 mmol/L (0. 8 – 1. 4) T Prot. 104 g/L (64 – 84) Alb 24 g/L (38 – 52) Globulin 80 g/L LDH 672 U/L (109 -193) T Bili 6 μmol/L (< 18) ALT 23 U/L (6 -37) AST 61 U/L (0 -30)

Results Serum Electrophoresis ● Increased monoclonal band in the gamma region ● Gammaglobulins is markedly reduced ● Others are pending

Requires 1 major + 1 minor criteria OR 3 minor criteria

References Kasper, D. L. , & Harrison, T. R. (2005). Harrison's principles of internal medicine. New York: Mc. Graw-Hill, Medical Pub. Division. Shah, D. (2018, January 11). Multiple Myeloma Treatment & Management. Retrieved April 23, 2018, from https: //emedicine. medscape. com/article/204369 treatment#d 8 Pick, A. , Wehrer, M. , & Nestrom, K. (2014). Multiple Myeloma: An Overview of the Disease and Treatment Options. US Pharm, 39(1), 7 -11. Retrieved April 23, 2018, from https: //www. uspharmacist. com/article/multiple-myeloma-an-overviewof-the-disease-and-treatment-options.
- Slides: 44